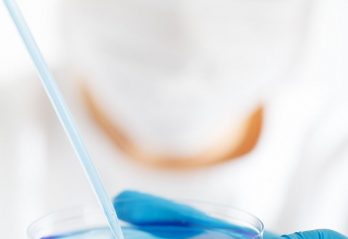

Alice Pettersson
Jag är Alice Pettersson, en passionerad skribent och copywriter med ett stort hjärta för språket och dess möjligheter att påverka, engagera och skapa verklig kontakt. Med en gedigen utbildning från Språkvetarprogrammet vid Uppsala Universitet har jag byggt en stark grund inom både lingvistik och kommunikation, vilket har gjort det möjligt för mig att utveckla ett skarpt öga för stil, tonalitet och målgruppsanpassning. Mitt nuvarande arbete på Klikko har gett mig chansen att kombinera min kärlek för språk med reklamvärldens dynamiska tempo – en perfekt kombination där jag får skapa texter som både informerar och inspirerar. Jag brinner för att berätta kraftfulla historier, oavsett om det gäller varumärkesbyggande innehåll, SEO-optimerade artiklar eller kampanjcopy. Genom att noggrant lyssna till kundens behov och analysera marknadens trender, strävar jag alltid efter att leverera skräddarsydda, kreativa och effektiva lösningar. Jag har haft privilegiet att arbeta med kunder från en mängd olika branscher, vilket har breddat mitt perspektiv och förmåga att anpassa mig till olika tonaliteter och kommunikationsmål. För mig är varje uppdrag en chans att skapa något som inte bara låter bra – utan också gör skillnad.